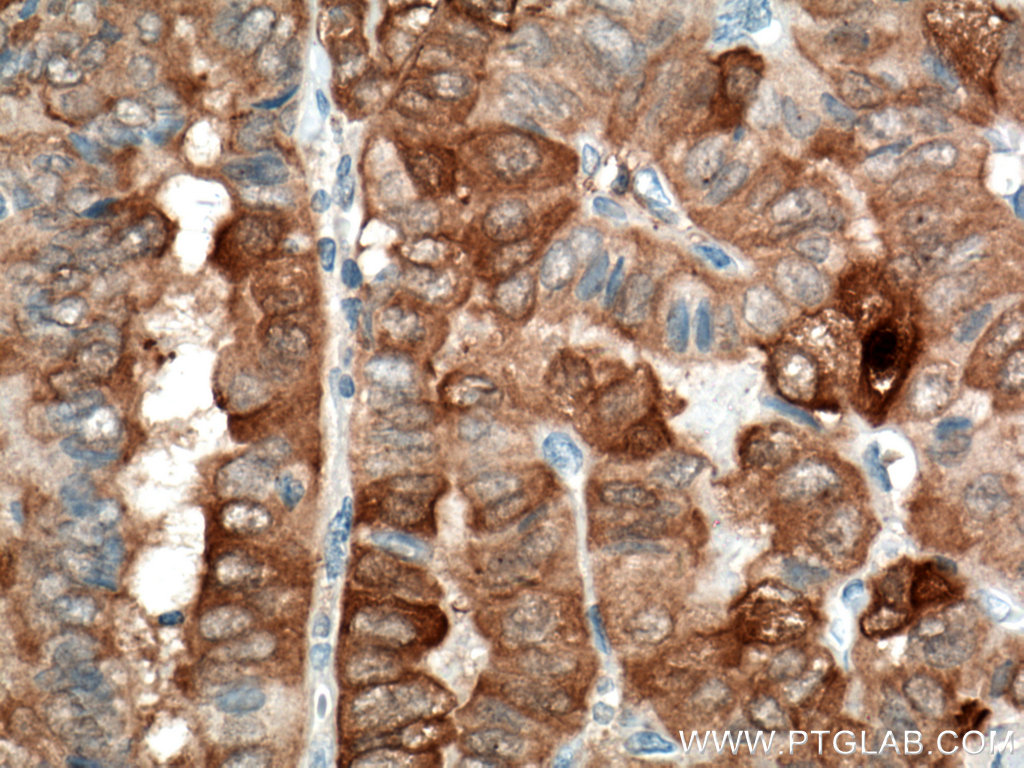

验证数据展示
经过测试的应用
| Positive WB detected in | A431 cells, HSC-T6 cells, HeLa cells, A549 cells, MCF-7 cells, T-47D cells, HepG2 cells, Caco-2 cells, human placenta tissue |
| Positive IHC detected in | human thyroid cancer tissue, human colon tissue, human ovary tumor tissue Note: suggested antigen retrieval with TE buffer pH 9.0; (*) Alternatively, antigen retrieval may be performed with citrate buffer pH 6.0 |
| Positive IF-P detected in | mouse kidney tissue, human thyroid cancer tissue |
| Positive IF/ICC detected in | HeLa cells, mouse kidney tissue, MCF-7 cells, human thyroid cancer tissue |
| Positive FC (Intra) detected in | HeLa cells |
推荐稀释比
| 应用 | 推荐稀释比 |
|---|---|
| Western Blot (WB) | WB : 1:5000-1:50000 |
| Immunohistochemistry (IHC) | IHC : 1:1000-1:4000 |
| Immunofluorescence (IF)-P | IF-P : 1:200-1:800 |
| Immunofluorescence (IF)/ICC | IF/ICC : 1:400-1:1600 |
| Flow Cytometry (FC) (INTRA) | FC (INTRA) : 0.80 ug per 10^6 cells in a 100 µl suspension |
| It is recommended that this reagent should be titrated in each testing system to obtain optimal results. | |
| Sample-dependent, Check data in validation data gallery. | |
产品信息
60207-1-Ig targets Galectin-3 in WB, IHC, IF/ICC, IF-P, FC (Intra), IP, CoIP, ELISA applications and shows reactivity with human, mouse samples.
| 经测试应用 | WB, IHC, IF/ICC, IF-P, FC (Intra), ELISA Application Description |
| 文献引用应用 | WB, IHC, IF, IP, CoIP |
| 经测试反应性 | human, mouse |
| 文献引用反应性 | human, mouse, rat |
| 免疫原 |
CatNo: Ag6753 Product name: Recombinant human Galectin 3 protein Source: e coli.-derived, PET28a Tag: 6*His Domain: 1-250 aa of BC001120 Sequence: MADNFSLHDALSGSGNPNPQGWPGAWGNQPAGAGGYPGASYPGAYPGQAPPGAYPGQAPPGAYPGAPGAYPGAPAPGVYPGPPSGPGAYPSSGQPSATGAYPATGPYGAPAGPLIVPYNLPLPGGVVPRMLITILGTVKPNANRIALDFQRGNDVAFHFNPRFNENNRRVIVCNTKLDNNWGREERQSVFPFESGKPFKIQVLVEPDHFKVAVNDAHLLQYNHRVKKLNEISKLGISGDIDLTSASYTMI 种属同源性预测 |
| 宿主/亚型 | Mouse / IgG2b |
| 抗体类别 | Monoclonal |
| 产品类型 | Antibody |
| 全称 | lectin, galactoside-binding, soluble, 3 |
| 别名 | 1C1B2, 35 kDa lectin, Carbohydrate-binding protein 35, CBP 35, CBP35 |
| 计算分子量 | 26 kDa |
| 观测分子量 | 31 kDa |
| GenBank蛋白编号 | BC001120 |
| 基因名称 | Galectin-3 |
| Gene ID (NCBI) | 3958 |
| RRID | AB_10951109 |
| 偶联类型 | Unconjugated |
| 形式 | Liquid |
| 纯化方式 | Protein A purification |
| UNIPROT ID | P17931 |
| 储存缓冲液 | PBS with 0.02% sodium azide and 50% glycerol, pH 7.3. |
| 储存条件 | Store at -20°C. Stable for one year after shipment. Aliquoting is unnecessary for -20oC storage. |
背景介绍
Galectins are a family of animal lectins defined by shared characteristic amino-acid sequences and affinity for β-galactose-containing oligosac-charides (PMID: 8063692). Galectin-3, a member of the β-galactoside-binding proteins, contains one carbohydrate recognition domain (CRD) and a proline- and glycine-rich N-terminal domain through which is able to form oligomers (PMID: 14758078). Galectin-3 is widely expressed in many normal tissues and a variety of tumors. It is found intracellularly in nucleus and cytoplasm or secreted outside of cell, being present on the cell surface or in the extracellular space (PMID: 16478649). Galectin-3 is involved in various biological processes including cell growth, adhesion, differentiation, apoptosis, angiogenesis, immune response, neoplastic transformation and metastasis (PMID: 16478649; 14758078).
实验方案
| Product Specific Protocols | |
|---|---|
| FC protocol for Galectin-3 antibody 60207-1-Ig | Download protocol |
| IF protocol for Galectin-3 antibody 60207-1-Ig | Download protocol |
| IHC protocol for Galectin-3 antibody 60207-1-Ig | Download protocol |
| WB protocol for Galectin-3 antibody 60207-1-Ig | Download protocol |
| Standard Protocols | |
|---|---|
| Click here to view our Standard Protocols |
发表文章
| Species | Application | Title |
|---|---|---|
Nat Commun Surplus fatty acid synthesis increases oxidative stress in adipocytes and lnduces lipodystrophy | ||
Cell Death Differ NLRX1 mediated impaired microglial phagocytosis of NETs in cerebral ischemia and reperfusion injury | ||
Cancer Res CD248 Regulates Wnt Signaling in Pericytes to Promote Angiogenesis and Tumor Growth in Lung Cancer | ||
Autophagy SMURF1 controls the PPP3/calcineurin complex and TFEB at a regulatory node for lysosomal biogenesis | ||
Circ. Res. Inhibition of KLF5-Myo9b-RhoA Pathway-Mediated Podosome Formation in Macrophages Ameliorates Abdominal Aortic Aneurysm. | ||
Acta Biomater Tumor cell membrane-based peptide delivery system targeting the tumor microenvironment for cancer immunotherapy and diagnosis. |